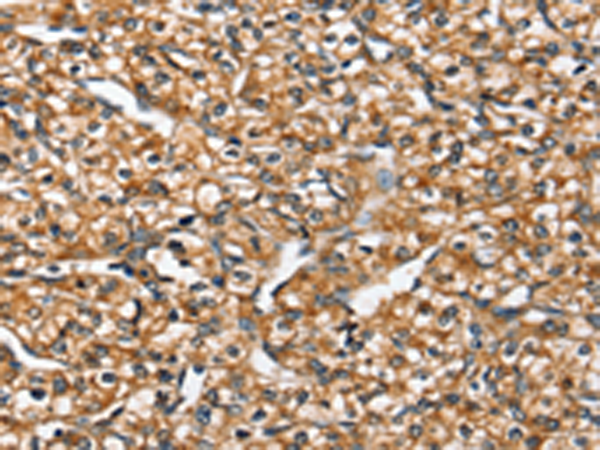

-
分类: 科研抗体货号: P12194别名: SLC41A1-L1应用: WB,IHC反应种属: Human, Mouse
-
分类: 科研抗体货号: P12191别名: ZIP3; ZIP-3应用: IHC反应种属: Human, Mouse, Rat
-
分类: 科研抗体货号: P12209别名: NPT1; NPT-1; NAPI-1应用: WB反应种属: Human
-
分类: 科研抗体货号: P12189别名: HHRH; NPTIIc应用: IHC反应种属: Human
-
分类: 科研抗体货号: P12226别名:应用: WB,IHC反应种属: Human, Mouse, Rat
-
分类: 科研抗体货号: P12208别名: NADC3; SDCT2应用: WB反应种属: Human
-
分类: 科研抗体货号: P12187别名: PRES; DFNB61应用: IHC反应种属: Human, Mouse, Rat
-
分类: 科研抗体货号: P12225别名: SDP3; Grd19; MCOPS8应用: WB,IHC反应种属: Human, Mouse, Rat
-
分类: 科研抗体货号: P12207别名: OATPB; OATP-B; OATP2B1; SLC21A9应用: IHC反应种属: Human
-
分类: 科研抗体货号: P12186别名:应用: IHC反应种属: Human

鄂公网安备42018502007531号
鄂公网安备42018502007531号

